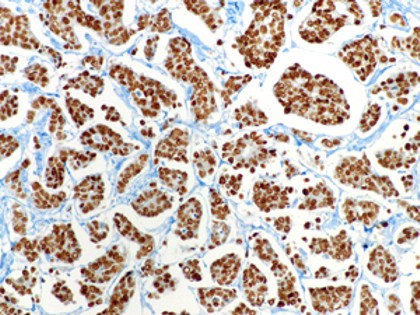

É il testosterone il «pillolo»
del futuro?
Sperimentato in
Cina. Risultati interessanti ma ci vorranno
anni per capire se la strada è giusta.
6 maggio 2009. -
Sarà il testosterone il «pillolo» del futuro? Ci vorranno ancora diversi
anni per saperlo, ma a puntarci , fra gli altri, sono alcuni ricercatori
cinesi, che sulla rivista Journal of Clinical Endocrinology & Metabolism
hanno dato conto di una loro sperimentazione fondata sull'iniezione di una
dose mensile dell'ormone maschile a scopo anticoncezionale, che, secondo
quando riferito, sarebbe efficace, avrebbe un effetto reversibile e non
darebbe grossi problemi collaterali nel breve periodo. «Per le coppie che
non possono o preferiscono non usare contraccettivi femminili - spiega il Yi-Qun
Gu dell'Istituto nazionale di ricerca per la pianificazione familiare di
Pechino - le opzioni ora sono limitate alla vasectomia, al preservativo o
all'astinenza. Il nostro studio dimostra invece che un contraccettivo
ormonale maschile può essere un'alternativa su cui lavorare e con buone
potenzialità».
6 maggio 2009. -
Sarà il testosterone il «pillolo» del futuro? Ci vorranno ancora diversi
anni per saperlo, ma a puntarci , fra gli altri, sono alcuni ricercatori
cinesi, che sulla rivista Journal of Clinical Endocrinology & Metabolism
hanno dato conto di una loro sperimentazione fondata sull'iniezione di una
dose mensile dell'ormone maschile a scopo anticoncezionale, che, secondo
quando riferito, sarebbe efficace, avrebbe un effetto reversibile e non
darebbe grossi problemi collaterali nel breve periodo. «Per le coppie che
non possono o preferiscono non usare contraccettivi femminili - spiega il Yi-Qun
Gu dell'Istituto nazionale di ricerca per la pianificazione familiare di
Pechino - le opzioni ora sono limitate alla vasectomia, al preservativo o
all'astinenza. Il nostro studio dimostra invece che un contraccettivo
ormonale maschile può essere un'alternativa su cui lavorare e con buone
potenzialità».
LO STUDIO - Nello studio sono stati coinvolti, secondo quanto affermato, uomini fertili in un buona salute, tra i 20 e 45 di età. Ognuno di loro aveva già avuto almeno un figlio nei due anni precedenti, mentre le loro partner avevano tra i 18 e 38 anni e normali funzioni riproduttive. Ogni mese, per 30 mesi, sono stati iniettati agli uomini 500 mg di testosterone undecanoato, osservando un tasso di gravidanza di 1,1 per 100 uomini in 24 mesi. Nessun effetto collaterale serio è stato segnalato, e le funzioni riproduttive sono ritornate normali in tutti i partecipanti, tranne due. «Nonostante questi risultati incoraggianti - conclude Gu - la sicurezza nel lungo periodo di un contraccettivo ormonale maschile richiede maggiori studi e analisi per quel riguarda le funzioni cardiovascolari, la prostata e i comportamenti di sicurezza».
MOLTA CAUTELA - Su una linea di grande prudenza il commento di Bruno Giammusso, responsabile dell'Unità operativa di andrologia dell'università di Catania, e membro della Società Italiana di Andrologia. «Il filone principale di ricerca sulla contraccezione maschile oggi in effetti punta sul testosterone» spiega l'esperto. «Il motivo è che con questo ormone è possibile sopprimere altri ormoni, prodotti dall'ipofisi, una ghiandola cerebrale, e in questo modo si può sopprimere la spermatogenesi. E l'effetto, in teoria, è reversibile». Tutto bene dunque? «Calma» sottolinea Giammusso. «Questa sperimentazione ci porterà forse , insieme ad altre, a qualche risultato fra diversi anni, ma per ora va sottolineato che il testosterone è un ormone potente, da maneggiare con molta cura». Quali sono i rischi? «Somministrandolo , tanto per cominciare, si agisce anche sulla prostata, e se una persona ha un tumore, anche piccolo in questa ghiandola e non lo sa, potrebbe subire un rapido peggioramento, quindi prima di assumerlo è comunque necessaria una visita specialistica con esplorazione rettale e un dosaggio del Psa nel sangue. Inoltre il testosterone sopra i normali livelli può provocare un aumento della viscosità del sangue, e quindi comportare problemi al cuore e alla circolazione. Infine, tanto per continuare con gli esempi, chi soffre di apnee notturrne può subire un pericoloso peggioramento della sua condizione, con un aumento della durata durate dei periodi senza respiro».
PALESTRE E AFFINI - Insomma parrebbe proprio che non ne valga la pena. «Bisogna distinguere: un conto è condurre una sperimentazione clinica con dosaggi controllati su soggetti precisi, che magari ci porterà a capire un giorno come usarlo , sotto stretto controllo, a scopo contraccettivo, un conto è pensare magari di poter ricorrere a questo ormone a scopo contraccettivo senza troppi pensieri» precisa Giammusso. «Basta vedere i rischi che corre chi usa ormoni in modo non controllato per gonfiare i muscoli: non si contano i casi di questo genere che osservano gli andrologi. Si tratta di persone che non sanno quello che fanno e che magari, oltre a problemi a cuore e prostata si ritrovano con una infertilità non sempre così facilmente reversibile».
(Corriere della Sera)